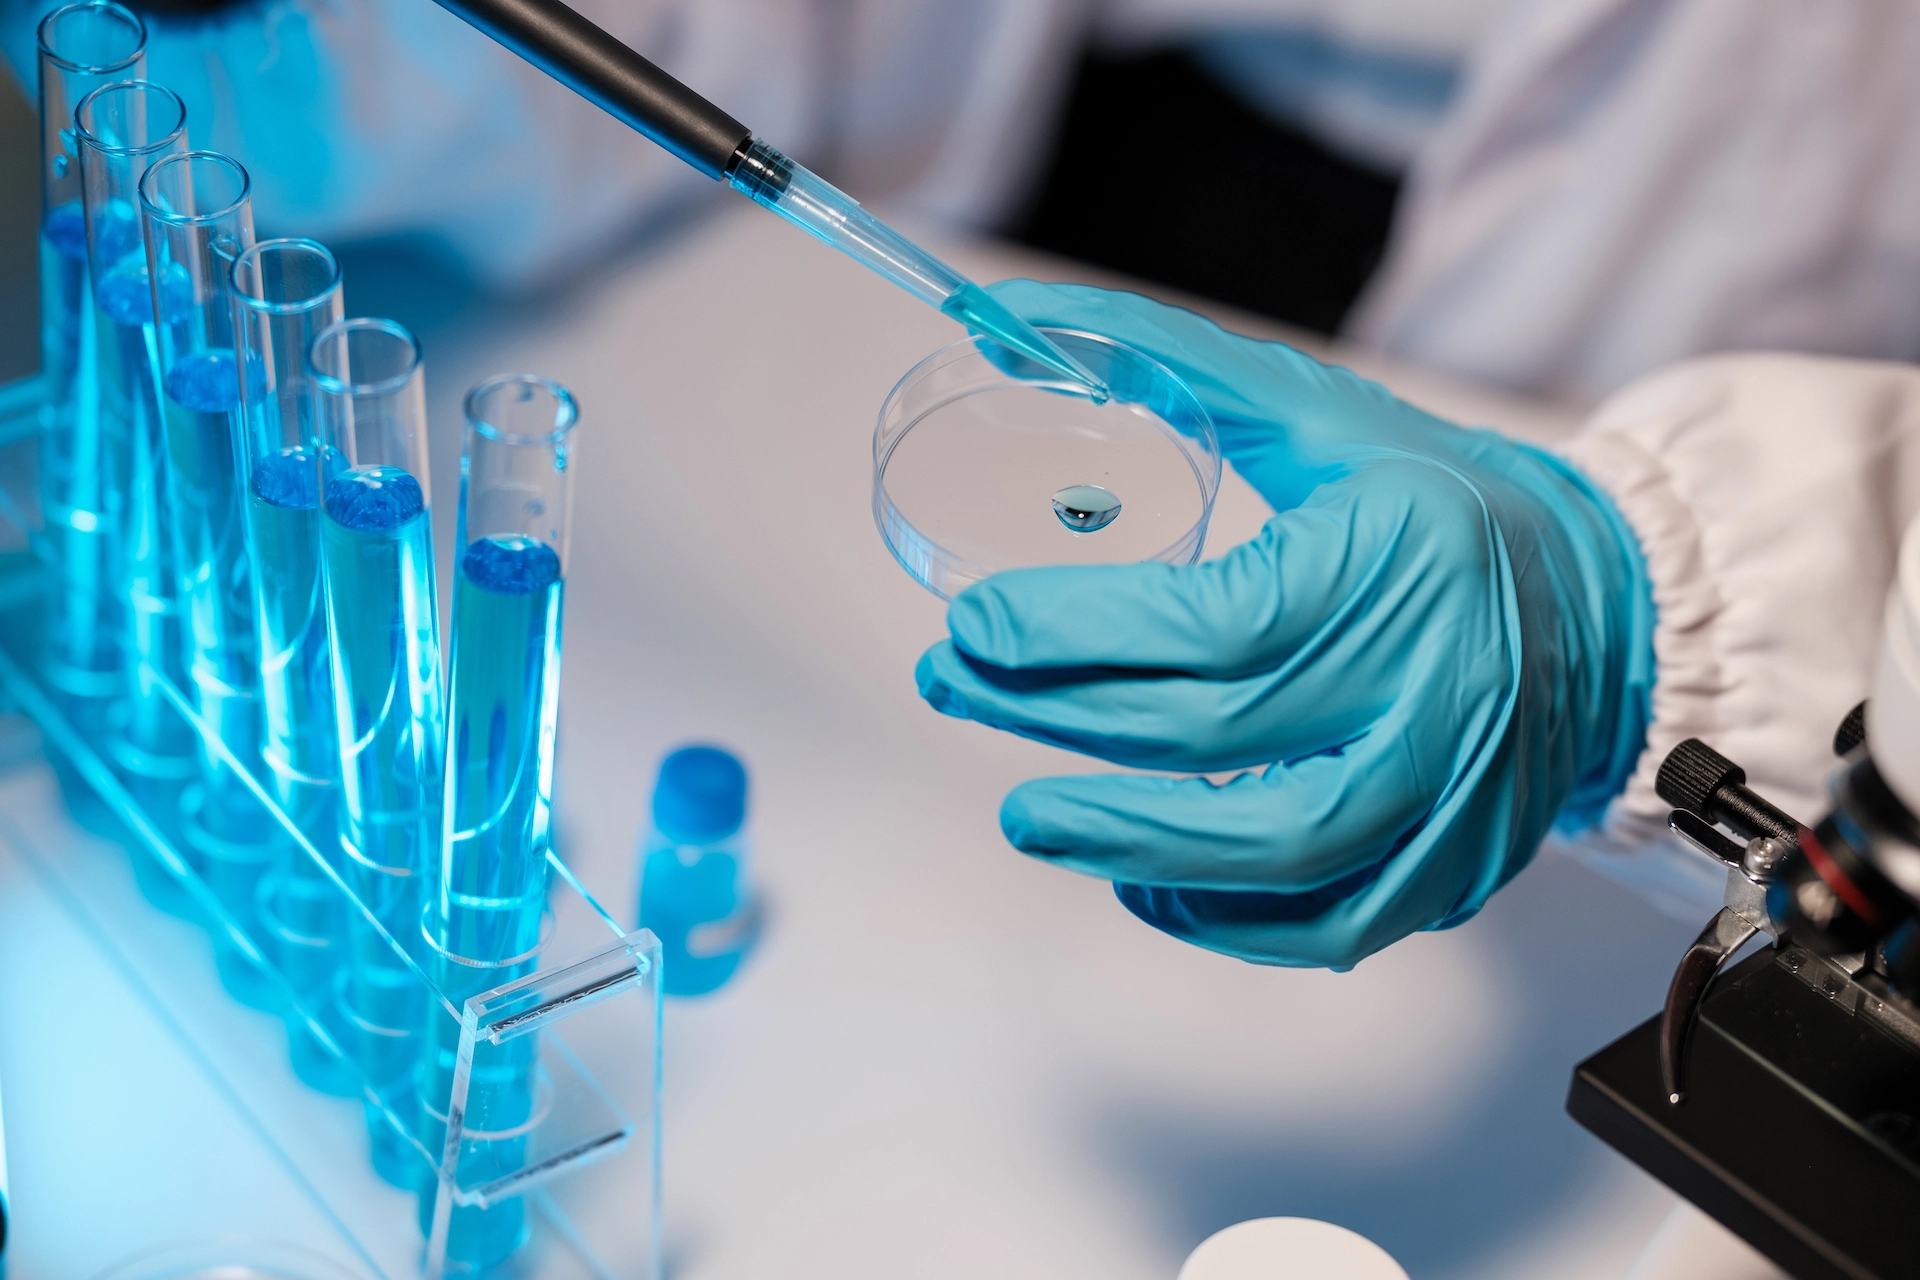
Osmose-Reversa-na-Indústria-Farmacêutica

A água é um componente vital em numerosos processos dentro da indústria farmacêutica, desde a formulação até a limpeza de equipamentos.
A qualidade da água utilizada é crítica para assegurar a eficácia e a segurança dos produtos. Neste contexto, a osmose reversa desempenha um papel indispensável na purificação da água, com destaque para o aspecto sanitário das membranas, que podem ser sanitizadas a temperaturas tão altas quanto 85 oC.
A osmose reversa é um método de purificação de água que emprega membranas semipermeáveis para eliminar contaminantes. Essas membranas permitem a passagem do solvente, como a água, enquanto atua como uma barreira para todos os sais, moléculas inorgânicas e moléculas orgânicas. Portanto, é um método altamente eficaz para eliminar contaminantes como:
-
Toxinas bacterianas / pirogênicos.
-
Inseticidas / pesticidas.
-
Herbicidas.
-
Antibióticos.
-
Nitratos.
-
Açúcares.
-
Sais solúveis.
-
Íons metálicos.
Uma das características mais importantes das membranas de osmose reversa na indústria farmacêutica é sua capacidade de serem sanitizadas termicamente. A sanitização térmica envolve a exposição das membranas a temperaturas elevadas, geralmente em torno de 85 oC. Este processo é altamente eficaz na eliminação de microrganismos, incluindo bactérias, vírus e fungos, garantindo a qualidade sanitária da água produzida.
A osmose reversa com membranas sanitizáveis termicamente é amplamente empregada na indústria farmacêutica devido à sua capacidade de fornecer água de alta pureza, essencial para uma variedade de aplicações críticas, tais como:
-
Formulação de Medicamentos: A água purificada é um ingrediente essencial em muitas formulações farmacêuticas.
-
Preparação de Soluções: Muitas soluções utilizadas no processo de fabricação de medicamentos exigem água de alta pureza.
-
Limpeza de Equipamentos: A limpeza eficaz de equipamentos e instalações é essencial para evitar a contaminação cruzada entre lotes de produtos farmacêuticos.
Benefícios da Sanitização Térmica das Membranas:
-
Garantia de Padrões Sanitários: A sanitização térmica das membranas assegura que a água produzida atenda aos mais altos padrões sanitários, livres de microrganismos prejudiciais à saúde.
-
Conformidade Regulatória: A utilização de membranas de osmose reversa sanitizáveis termicamente auxilia as empresas farmacêuticas a cumprir as regulamentações sanitárias rigorosas, contribuindo para a conformidade com as Boas Práticas de Fabricação (BPF).
-
Segurança do Produto: A água purificada produzida por meio de osmose reversa com membranas sanitizáveis termicamente contribui para a segurança e eficácia dos produtos farmacêuticos, minimizando o risco de contaminação microbiológica.
A osmose reversa desempenha um papel importante na indústria farmacêutica, proporcionando uma fonte confiável de água purificada por meio da sanitização térmica das membranas. Essa abordagem garante a qualidade e a segurança da água utilizada em diversos processos, contribuindo para a produção de medicamentos de alta qualidade e a conformidade com os padrões regulatórios.
Autor: Joaquim Marques Filho, M. Sc.